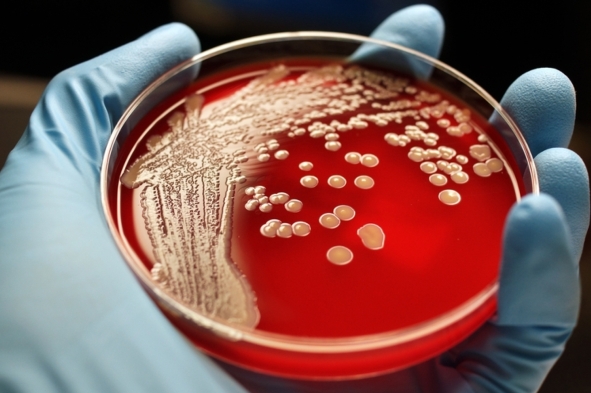

作者:Dina Fine Maron on September 7, 2016
导语:
愈演愈烈的抗生素耐药性使得它成为即将于本月举行的全球政府首脑峰会的唯一主题。
图注:血琼脂培养基上的MARS菌落
(MARS,Methicillin-resistant Staphylococcus aureus,耐甲氧西林的金黄色葡萄球菌)
图片来源:RPARULAN JR. Getty Images
一周中有很多次,Brad Spellberg都需要做出艰难的抉择。一位来自南加州的病人由于同样的症状:小便不畅伴随疼痛,全身发热,同时感到恶心反胃——被送进了急救室。基于这些症状,Spellberg可以迅速做出(急性体现在哪?)肾脏感染的诊断,但是问题在于接下来他该怎么做。他明白病人的痛苦并且非常想要给予帮助,但他需要考虑的不仅仅是病人的健康问题。
和所有急诊科大夫一样,Spellberg可以有两个不同的选择。其一,静脉给予强效抗生素碳青霉烯。它具有广谱抗菌作用,但是会导致一个棘手的问题。这种宝贵的药物一旦使用,就不太可能继续用在该病人身上。原因在于这种药物在杀死敏感的细菌同时也会诱发耐药性,即经过碳青霉烯的作用少数存活下来的耐药菌会大量繁殖。还有一个选择是给病人开据(抗菌)效果稍差的喹诺酮,让病人出院。而这个决定存在很高的风险。如果病人体内的病菌毒力较弱,喹诺酮可以控制它,那么病人就会康复。一旦其感染是由于耐药菌引起的,如果不给予碳青霉烯,病人将无法康复同时感染也会加重。
Spellberg所冒的风险在于如何把控时机。由于没有快速、廉价的诊断方法可用,他还未搞清楚是什么原因导致患者感染了这么多天。实验室的工作人员还需要三天时间才能鉴别出引起患者感染的致病菌。然而,Spellberg无法等那么长时间后才做出决定。令人担忧的是,他所面临的困境是普遍存在的。整个美国的医生们都被同样的问题所困扰,每个人都像旧金山郡的南加州大学医学中心(给出研究机构的原名)的首席医疗主管一样忧心忡忡。
现在的处境提示我们是时候控制抗生素的耐药性了。已经有越来越多的事实表明情况不容乐观。今年8月,世界卫生组织出台了新版性传播疾病防治指南。该指南指出此前针对淋病(一种由淋病球菌引起的以泌尿生殖系化脓性感染为主要表现的性传播疾病)的标准治疗药物由于耐药菌的不断涌现已经无法达到治疗效果。现在世卫组织推荐使用另外两种药物治疗淋病感染。此外,根据世卫组织早期的研究结果显示抗生素耐药菌已经遍布世界上每一个角落,这将会危害百年来医学已经取得的进步。
抗生素耐药性带来的威胁如此骇人以至于联合国大会(the United Nations General Assembly)特地于本月在纽约市召开了相关会议。尽管世卫组织已连续多年发出抗生素耐药性的警报,本月的高级别联合国会议依然代表着联合国历史上少有的,第四次在原本以战争和经济为主题举办的全球协商大会上,举办以解决健康问题为中心的会议。(其他三次的主题分别是艾滋病、非传染性疾病和埃博拉)。来自宾夕法尼亚大学(Universityof Pennsylvania)医学伦理与健康政策学的教授EzekielEanuel表示这次会议让人们清晰地认识到抗生素耐药性是一个全球性的威胁,我们需要每一个人都行动起来。
最近几年,要求举行这种高级别会议的呼声越来越高,同时医疗行业和农业生产活动中不必要或者错误的抗生素滥用也使得问题进一步恶化。以农业生产为例,一些生产者给健康的牲畜或者鱼类食用抗生素以加快它们的生长使他们在较差的饲养条件中保持健康。这种做法导致的耐药性会造成一些针对人类的药物也无法继续使用。
新的警报
于9月21日举行的联合国会议将宣布关于超级细菌的最新消息。去年十一月,一篇发表在《柳叶刀 感染性疾病》(《TheLancet Infectious Disease》)上的研究报告显示科学家已经在中国人群和肉用动物身上观察到针对最后一类抗生素黏菌素的耐药菌,原因可能是为了加速农业生产而给牲畜喂食黏菌素。耐药基因存在于质粒上,它由一段DNA组成,可以轻易地在不同种类的细菌之间传递。噩耗接踵而至:近几个月来,我们发现针对黏菌素的耐药基因已经在全球许多地区流行开来。
耐黏菌素的大肠杆菌已经在超过30个国家出现,包括一位来自美国的患者。英国的一株大肠杆菌已经证实可以同时耐受碳青霉烯和黏菌素。(幸运的是,该株细菌对于其余的抗生素是敏感的)“人们如此关注黏菌素耐药性是由于我们已经开始感到绝望”,乔治华盛顿大学的微生物学家,担任抗生素耐药性行动中心(Antibiotic Resistance Action Center )主任的Lance Price,如此说道:“黏菌素是一种疗效较差的药物。具有较大毒性,医生并不喜欢它,但是现在他们不得不使用它,因为这是唯一可以治疗耐药菌感染的药物。”
开拓抗菌兵工厂
世卫组织抗生素耐药性总干事特别代表Keiji Fukuda表示即将进行的联合国会议旨在强调(控制)抗生素耐药性的重要性和高优先性。Fukuda解释说:“之前的讨论只在卫生和农业部长之间开展,此次会议的级别将上升到总理和主席层面”。然而本次会议希望实施的行动目前还只是在酝酿阶段。(会议)所达成的协议并没有约束力。Fukuda表示,通过政治宣讲承诺进一步协调该问题可能是更切合实际的做法。他说:“这件事看似简单,但是要想在全球范围内达成协作是十分困难的”。此外,这次讨论也会尽力解决保障项目运行的资金问题。
然而,愈演愈烈的抗生素耐药性并没有随国际外交活动的(迟缓)步伐而停滞。一类新型抗生素的引入已经过去数十年。随着越来越多的致病菌对现有抗菌药物产生耐药性,人们迫切需要(又一个)新药物的出现。研究者表示新型抗生素可能不是唯一的选择。一些新的(抗菌)武器正在研发中,可以和抗生素合并使用,其中包括利用微小的,能够寄生于细菌的噬菌体来对抗病原菌。研究团队也寄希望于开发高效的抗体抵抗一些特异性感染或者发明一种能够调节人类对于某种病原菌免疫力的药物,考虑到在某些细菌感染中抑制炎症反应可能有助于减轻感染导致的损伤。Spellberg谈到,还有一种方法是利用铁吸附技术(即使用含铁吸附剂除去细菌生长必须的物质),导致细菌能量耗竭至死,使其无法在人体内繁殖。Price也在进行其他相关研究。还有人着眼于肠道菌群,希望改造一种益生菌可以改变或者抑制有害细菌的定植。“在和抗生素耐药性的战斗中只有一个灵丹妙药是远远不够的”,Spellberg说,“还有许多事情需要我们去做,这样那些最有效的解决方案才能不断涌现”。
抗生素耐药的风险已经开始渗透进我们的日常生活,这是在医疗机构和农场之外,也是最容易被忽视,值得我们提高警惕的。Spellberg表示,还有一个谈论较少的问题是社区获得性感染,在社区,人们通过食物、饮用水所或者手接触被污染的物体表面后触摸口唇的方式传播超级细菌。患者都是在无意中感染了超级细菌,感染后细菌定植在肠道长达几周甚至几年但不引起任何症状。只有当这些超级细菌移位到身体的其他部位,例如尿道时,它们才会产生危害甚至使人丧命。
不幸的是,由于菌群易位导致的感染正在以惊人的速度蔓延开来。最近的一项小型调查发现有近三分之一的感染患者对于主要的抗生素(包括青霉素和碳青霉烯)耐药,但是他们不存在典型的耐药风险,包括曾经暴露在医疗机构中,或者有抗生素服用史以及进行过跨国旅游。这表明他们是在自己生活的社区感染了超级细菌,而社区中的病菌显然正在以一种难以察觉的方式流行。
许多能够采取的措施正在实行中,希望能够合力控制住抗生素耐药性的持续增长。其中之一是缩短用药周期,使用能控制住感染的最小剂量。(长期用药会给体内的病菌造成生存压力,诱导耐药性的产生。)美国感染性疾病协会,近期修改了医院获得性和社区获得性肺炎的防治指南。根据最新的科学研究,将建议治疗时间缩短到7天甚至更短。(他们相信)这足够使病人恢复健康。尽管如此,Spellberg担心许多诸如此类的建议只是纸上谈兵,并没有付诸实践。他提出,消费者们可以采取一些自我保护措施确保现存的药物未来对自己有效,例如常洗手、清洗蔬菜、咨询医生抗生素是否必须使用,注射疫苗预防感染等。
也许目前最棘手的问题依然是如何吸引足够的资金投入到这场对抗超级细菌的战斗中。Fukuda表示:“针对超级细菌的研究是必要的,然而我们没有与之对应的商业化模式来支撑和鼓励其发展。”医药生产商常常将一句话挂在嘴边,那就是——没有一个激励性政策,例如政府对于研发新型抗生素给予奖励,针对抗生素的投入就没有商业价值。与之相比,他们更愿意着眼于那些有更高利润(例如新型抗癌药物)的项目中。
然而,事实是,在Spellberg的急诊室中,病人已经承受不住更多的等待。
原文链接:
http://www.scientificamerican.com/article/superbug-explosion-triggers-u-n-general-assembly-meeting/
翻译:张银连
审校:方露









留言